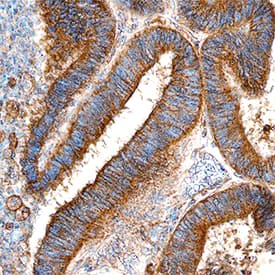
Ets-1 antibody in Human Ovary by Immunohistochemistry (IHC-P).

Human/Mouse/Rat Ets-1 Antibody
R&D Systems, part of Bio-Techne | Catalog # AF7284


Key Product Details
Species Reactivity
Applications
Label
Antibody Source
Product Specifications
Immunogen
Glu127-Val230
Accession # P14921
Specificity
Clonality
Host
Isotype
Scientific Data Images for Human/Mouse/Rat Ets-1 Antibody
Detection of Human, Mouse, and Rat Ets-1 by Western Blot.
Western blot shows lysates of Jurkat human acute T cell leukemia cell line, human thymus tissue, mouse thymus tissue, and rat CD4+T cells. PVDF membrane was probed with 0.5 µg/mL of Sheep Anti-Human/Mouse/Rat Ets-1 Antigen Affinity-purified Polyclonal Antibody (Catalog # AF7284) followed by HRP-conjugated Anti-Sheep IgG Secondary Antibody (Catalog # HAF016). A specific band was detected for Ets-1 at approximately 54 kDa (as indicated). This experiment was conducted under reducing conditions and using Immunoblot Buffer Group 1.Ets‑1 in Human Ovary.
Ets-1 was detected in immersion fixed paraffin-embedded sections of human ovary using Sheep Anti-Human/Mouse/Rat Ets-1 Antigen Affinity-purified Polyclonal Antibody (Catalog # AF7284) at 5 µg/mL for 1 hour at room temperature followed by incubation with the Anti-Sheep IgG VisUCyte™ HRP Polymer Antibody (Catalog # VC006). Tissue was stained using DAB (brown) and counterstained with hematoxylin (blue). Specific staining was localized to plasma membrane in epithelial cells. View our protocol for IHC Staining with VisUCyte HRP Polymer Detection Reagents.Applications for Human/Mouse/Rat Ets-1 Antibody
Immunohistochemistry
Sample: Immersion fixed paraffin-embedded sections of human ovary
Western Blot
Sample: Jurkat human acute T cell leukemia cell line, human thymus tissue, mouse thymus tissue, and rat CD4+ T cells
Formulation, Preparation, and Storage
Purification
Reconstitution
Formulation
Shipping
Stability & Storage
- 12 months from date of receipt, -20 to -70 °C as supplied.
- 1 month, 2 to 8 °C under sterile conditions after reconstitution.
- 6 months, -20 to -70 °C under sterile conditions after reconstitution.
Background: Ets-1
Ets-1 (E26 Transformation-Specific 1; also p54 and c-ets1) is a 52-54 kDa member of the ETS family of proteins. It is found in multiple cell types, and serves as a transcriptional regulator (generally activator) of multiple target genes, including prolactin, the transferrin receptor, and Cyclin E. By upregulating Cyclin E and CDK2 genes, it promotes cell-cycle progression. Ets‑1 forms complexes with both transcriptional activators (AP-1 and GHF-1) and repressors (MafB and Daxx). Human Ets‑1 is 441 amino acids (aa) in length. It contains one PNT domain (aa 51-136) that binds ERK2, and a DNA-binding ETS domain (aa 335-415). There are two SUMOylation sites, plus four utilized phosphorylation and acetylated lysine sites. At least four potential isoform variants are reported. One shows a deletion of aa 244-330 (termed isoform 1B), a second shows a deletion of aa 262-331, a third contains a deletion of aa 28-244, and a fourth possesses an 11 aa substitution for aa 262-441. Over aa 127-230, human Ets‑1 shares 95% aa identity with mouse Ets‑1.
Long Name
Alternate Names
Gene Symbol
UniProt
Additional Ets-1 Products
Product Documents for Human/Mouse/Rat Ets-1 Antibody
Product Specific Notices for Human/Mouse/Rat Ets-1 Antibody
For research use only